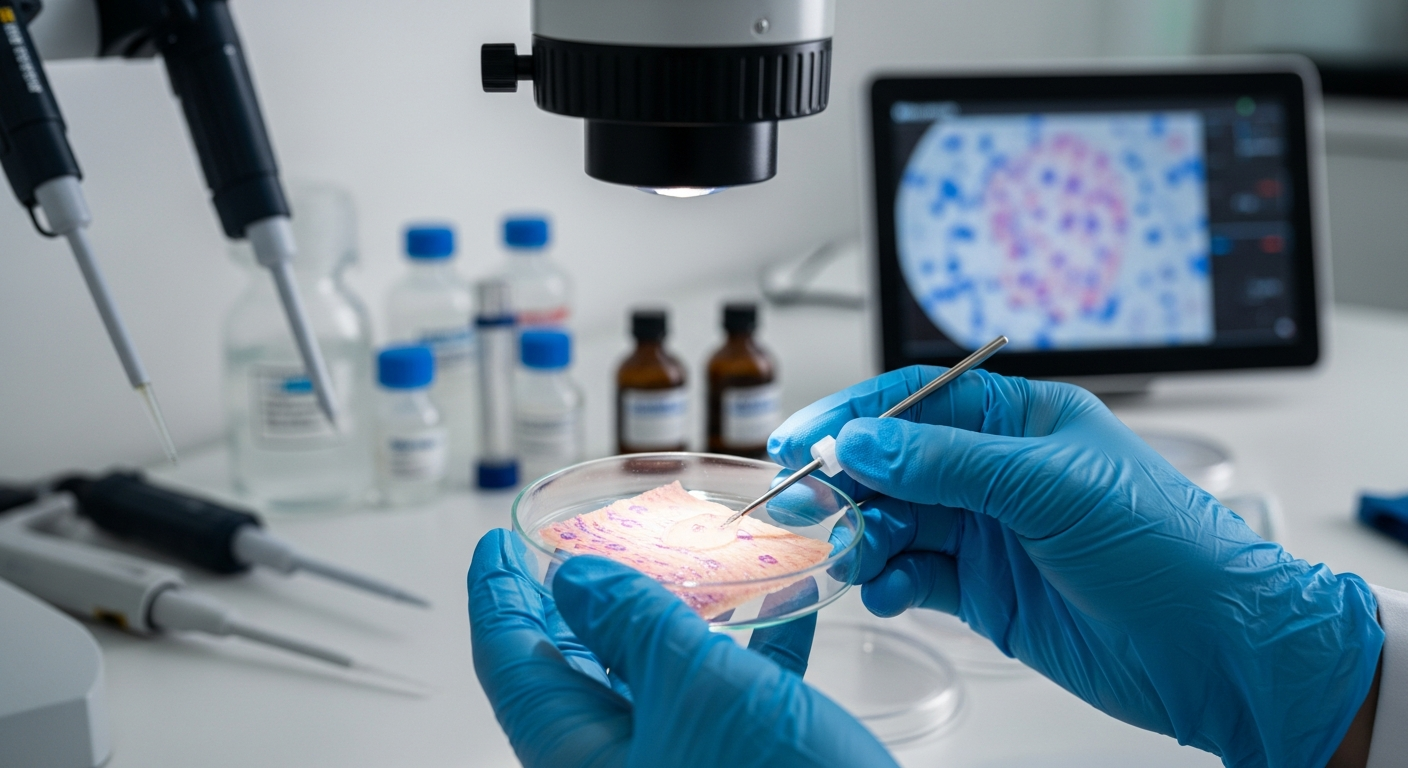

The Science of Skin Health and Vitality
Understanding the intricate relationship between our internal bodily functions and external skin appearance is key to achieving lasting skin health and vitality. Our skin, the body's largest organ, acts as a protective barrier and a visible indicator of overall wellbeing. This article delves into the scientific principles that underpin healthy skin, exploring how various lifestyle factors contribute to its radiance and resilience.
The pursuit of vibrant skin often leads to an exploration of various products and treatments, yet the true foundation of skin health and vitality lies in a holistic approach that encompasses both internal and external factors. Skin, as a complex organ, reflects our overall physiological state, making its condition a significant indicator of general wellness and health.
How Overall Wellness and Health Influence Skin Appearance
Our skin is intimately connected to our internal systems. A balanced state of wellness and health directly translates into the skin’s appearance, contributing to its natural radiance. Chronic stress, for instance, can trigger inflammation, which may manifest as acne, eczema, or premature aging. The body’s ability to repair and regenerate cells, including skin cells, is optimized when internal systems are functioning efficiently. This includes strong immune responses and efficient waste elimination, both of which are crucial for maintaining clear, healthy skin. Prioritizing overall wellbeing through adequate rest, stress management, and preventative care helps to support the skin’s natural protective and regenerative processes.
The Role of Skincare, Hydration, and Daily Routines
External skincare practices play a fundamental role in protecting the skin from environmental stressors and maintaining its integrity. A consistent routine tailored to individual skin types can significantly improve texture, tone, and overall aesthetics. Essential components often include cleansing, moisturizing, and sun protection. Beyond topical applications, adequate internal hydration is paramount. Water intake directly influences skin elasticity and plumpness, helping to prevent dryness and dullness. When skin cells are properly hydrated, they can perform their barrier functions more effectively, leading to a smoother, more supple complexion and contributing to a healthy glow.
Exercise and Movement for Enhanced Skin Vitality
Physical exercise is not just beneficial for muscle strength and cardiovascular performance; it also significantly impacts skin vitality. Regular movement increases blood flow, which delivers oxygen and nutrients to skin cells while carrying away waste products. This improved circulation can give the skin a healthy flush and promote cell turnover, contributing to a more youthful and vibrant appearance. Additionally, exercise can help regulate hormones and reduce stress, both of which have positive effects on skin health. Engaging in consistent training can foster a sustained improvement in skin quality over time, enhancing its natural resilience.
Nutrition and Lifestyle Choices for a Healthy Complexion
What we consume and how we live our lives profoundly affects our skin. A balanced nutrition plan, rich in antioxidants, vitamins, and healthy fats, provides the building blocks for healthy skin cells and protects against oxidative damage. Foods high in omega-3 fatty acids, for example, can help reduce inflammation and maintain skin barrier function. Conversely, diets high in processed foods and sugar can exacerbate skin issues. Beyond diet, broader lifestyle choices, such as avoiding smoking and limiting alcohol consumption, are critical for maintaining skin health. These choices contribute to the skin’s ability to maintain its natural glow and overall vitality.
Mindfulness and Selfcare in Promoting Skin Health
The connection between the mind and skin is increasingly recognized, highlighting the importance of mindfulness and selfcare for skin health. Chronic stress can trigger a cascade of physiological responses that negatively impact the skin, including increased cortisol levels which can lead to oil production and inflammation. Practicing mindfulness through meditation, deep breathing, or yoga can help reduce stress, thereby mitigating its detrimental effects on the skin. Engaging in selfcare rituals, whether it’s a relaxing bath or a dedicated skincare routine, provides moments of calm and self-attention, fostering a sense of peace that can positively reflect on skin radiance and overall wellbeing.
Achieving optimal skin health and vitality is a journey that integrates various aspects of our lives. From the nutrients we consume and the hydration we maintain, to our physical activity levels and stress management techniques, every choice contributes to the overall condition of our skin. By adopting a holistic approach that nurtures both internal wellbeing and external care, individuals can support their skin’s natural functions and enhance its inherent beauty and resilience.






